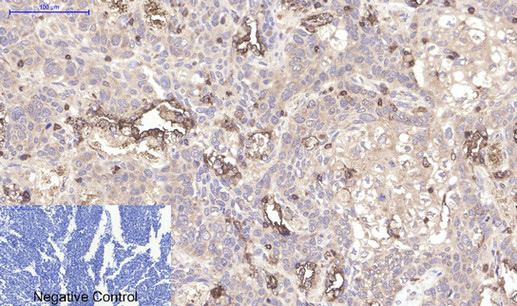
Immunohistochemical analysis of paraffin-embedded Human-lung-cancer tissue. 1,CD45 Monoclonal Antibody(12A9) was diluted at 1:200(4°C,overnight). 2, Sodium citrate pH 6.0 was used for antibody retrieval(>98°C,20min). 3,Secondary antibody was diluted at 1:200(room tempeRature, 30min). Negative control was used by secondary antibody only.

-
Product Name
Anti-CD45 (8C1) Mouse antibody
- Documents
-
Description
CD45 (8C1) Mouse monoclonal antibody
-
Tested applications
ICC/IF, WB, IHC-P
-
Species reactivity
Human
-
Isotype
Mouse IgG1
-
Preparation
Antigen: Synthetic Peptide of CD45
-
Clonality
Monoclonal
-
Formulation
PBS, pH 7.4, containing 0.02% sodium azide as Preservative and 50% Glycerol.
-
Storage instructions
Store at 4°C short term. Store at -20°C long term. Avoid freeze / thaw cycle.
-
Applications
IF: 1/50-200
WB: 1/2000
IHC: 1/50-300
-
Validations

Western blot analysis of Hela, diluted at 1:2000.

Western blot detection of CD45 in Jurkat cell lysates using CD45 (8C1) Mouse mAb(1:1000 diluted).Predicted band size:147KDa.Observed band size:180 to 240KDa.
Immunohistochemical analysis of paraffin-embedded Human-lung-cancer tissue. 1,CD45 Monoclonal Antibody(12A9) was diluted at 1:200(4°C,overnight). 2, Sodium citrate pH 6.0 was used for antibody retrieval(>98°C,20min). 3,Secondary antibody was diluted at 1:200(room tempeRature, 30min). Negative control was used by secondary antibody only.

Immunofluorescence analysis of human-liver-cancer tissue. 1,CD45 Monoclonal Antibody(12A9)(red) was diluted at 1:200(4°C,overnight). 2, Cy3 labled Secondary antibody was diluted at 1:300(room temperature, 50min).3, Picture B: DAPI(blue) 10min. Picture A:Target. Picture B: DAPI. Picture C: merge of A+B
-
Background
Swiss-Prot Acc.P06800.Protein tyrosine-protein phosphatase required for T-cell activation through the antigen receptor. Acts as a positive regulator of T-cell coactivation upon binding to DPP4. The first PTPase domain has enzymatic activity, while the second one seems to affect the substrate specificity of the first one. Upon T-cell activation, recruits and dephosphorylates SKAP1 and FYN . Dephosphorylates LYN, and thereby modulates LYN activity.
Related Products / Services
Please note: All products are "FOR RESEARCH USE ONLY AND ARE NOT INTENDED FOR DIAGNOSTIC OR THERAPEUTIC USE"
